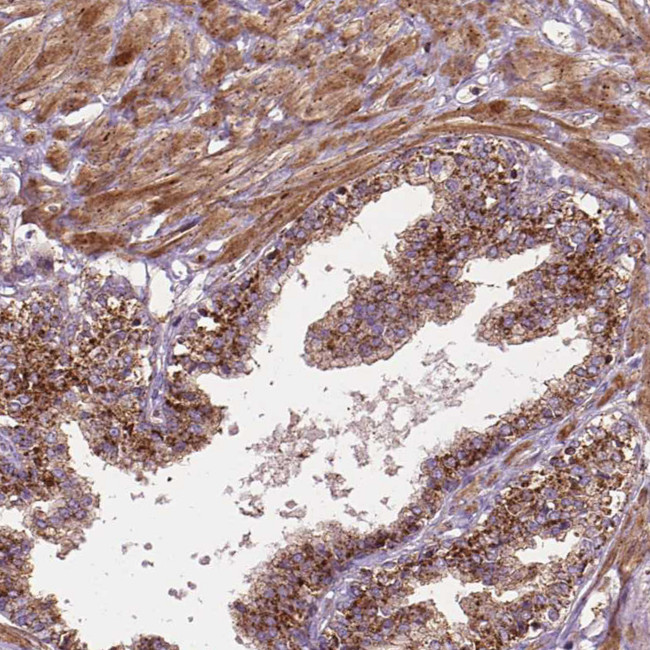
CHMP4A Antibody in Immunohistochemistry (Paraffin) (IHC (P))

Search
Invitrogen
CHMP4A Polyclonal Antibody
{{$productOrderCtrl.translations['antibody.pdp.commerceCard.promotion.promotions']}}
{{$productOrderCtrl.translations['antibody.pdp.commerceCard.promotion.viewpromo']}}
{{$productOrderCtrl.translations['antibody.pdp.commerceCard.promotion.promocode']}}: {{promo.promoCode}} {{promo.promoTitle}} {{promo.promoDescription}}. {{$productOrderCtrl.translations['antibody.pdp.commerceCard.promotion.learnmore']}}
产品信息
PA5-64372
种属反应
宿主/亚型
分类
类型
抗原
偶联物
形式
浓度
规格
纯化类型
保存液
内含物
保存条件
运输条件
RRID
产品详细信息
Immunogen sequence: THLPAGPAPK VDEDEEALKQ LAEWVS
Highest antigen sequence identity to the following orthologs: Mouse - 46%, Rat - 42%.
靶标信息
Probable core component of the endosomal sorting required for transport complex III (ESCRT-III) which is involved in multivesicular bodies (MVBs) formation and sorting of endosomal cargo proteins into MVBs. MVBs contain intraluminal vesicles (ILVs) that are generated by invagination and scission from the limiting membrane of the endosome and mostly are delivered to lysosomes enabling degradation of membrane proteins, such as stimulated growth factor receptors, lysosomal enzymes and lipids. The MVB pathway appears to require the sequential function of ESCRT-O, -I,-II and -III complexes. ESCRT-III proteins mostly dissociate from the invaginating membrane before the ILV is released. The ESCRT machinery also functions in topologically equivalent membrane fission events, such as the terminal stages of cytokinesis and the budding of enveloped viruses (HIV-1 and other lentiviruses). ESCRT-III proteins are believed to mediate the necessary vesicle extrusion and/or membrane fission activities, possibly in conjunction with the AAA ATPase VPS4. When overexpressed, membrane-assembled circular arrays of CHMP4A filaments can promote or stabilize negative curvature and outward budding. Via its interaction with PDCD6IP involved in HIV-1 p6- and p9-dependent virus release.
仅用于科研。不用于诊断过程。未经明确授权不得转售。
篇参考文献 (0)
生物信息学
蛋白别名: Charged multivesicular body protein 4a; CHMP4a; chromatin modifying protein 4A; Chromatin-modifying protein 4a; hSnf-1; hVps32-1; similar to yeast Snf7p; SNF7 homolog associated with Alix-2; Snf7 homologue associated with Alix 2; SNF7-1; Vacuolar protein sorting-associated protein 32-1; Vps32-1
基因别名: C14orf123; CDA04; CHMP4; CHMP4A; CHMP4B; hSnf7-1; HSPC134; SHAX2; SNF7; SNF7-1; VPS32-1; VPS32A
UniProt ID: (Human) Q9BY43
Entrez Gene ID: (Human) 29082